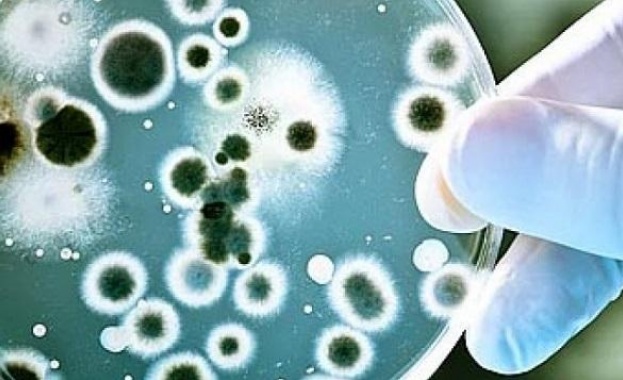
Откриха бактерии на 4 млн. години в една от най-дълбоките пещери

-
 05 Юли 2026 |
05 Юли 2026 |
 USD / BGN 1.1448
USD / BGN 1.1448 GBP / BGN 0.8572
GBP / BGN 0.8572 CHF / BGN 0.9190
CHF / BGN 0.9190- Радиация: София 0.11 (µSv/h)
- Времето:
 София 0°C
София 0°C 
Откриха бактерии на 4 млн. години в една от най-дълбоките пещери
24 Декември 2016 | 15:32
/КРОСС/ Учени откриха древен щам на бактерия, наречена Paenibacillus, в една от най-дълбоките пещери на света. Тя изглежда устойчива на най-силните антибиотици на съвременната медицина.
Бактериите са били скрити в продължение на повече от 4 млн. години, което предполага, че могат да развият резистентност към някои видове медикаменти чрез излагане на естествено срещащи се антибиотици в подземната околна среда.
Бактериите са открити на 305 метра под земята в пещерата Лечугуила в Ню Мексико - среда, която се смята за девствена и има голямо научно значение.
Учени от университетите „Акрон" в Охайо и „Макмастър" в Канада използвали пещерни образци, които да идентифицират пет конкретни начина, чрез които Paenibacillus проявява устойчивост срещу лекарствата.
"Идентифицирахме някои уникални механизми на резистентност, които дори не са се появили в бактерии", обяснява изследователят Хейзъл Бартън.
Антибиотиците работят чрез блокиране на механизмите на вредните бактерии, но проблемът е, че тези патогени се развиват бързо. Другият проблем е, че масовото увеличение в употребата на антибиотици в болниците и отрасли като селското стопанство, помага на антибиотично резистентните патогени да се развиват още по-бързо. Това е част от причината, поради която този щам на древни бактерии представлява толкова голям интерес.
Тестовете показват, че бактериите са резистентни към 18 различни антибиотици, включително даптомицин, използван като "последна инстанция", когато всички други медикаменти не помогнат.
Основната защита, използвана от Paenibacillus, е производството на мутации в отделни клетки, които след това се предават на следващото поколение.
Изследователите казват, че пещерата Лечугуила приютява древни, устойчиви на лекарства бактерии, и може също така да съдържа съставките за нови антибиотици.
Източник: БНТ